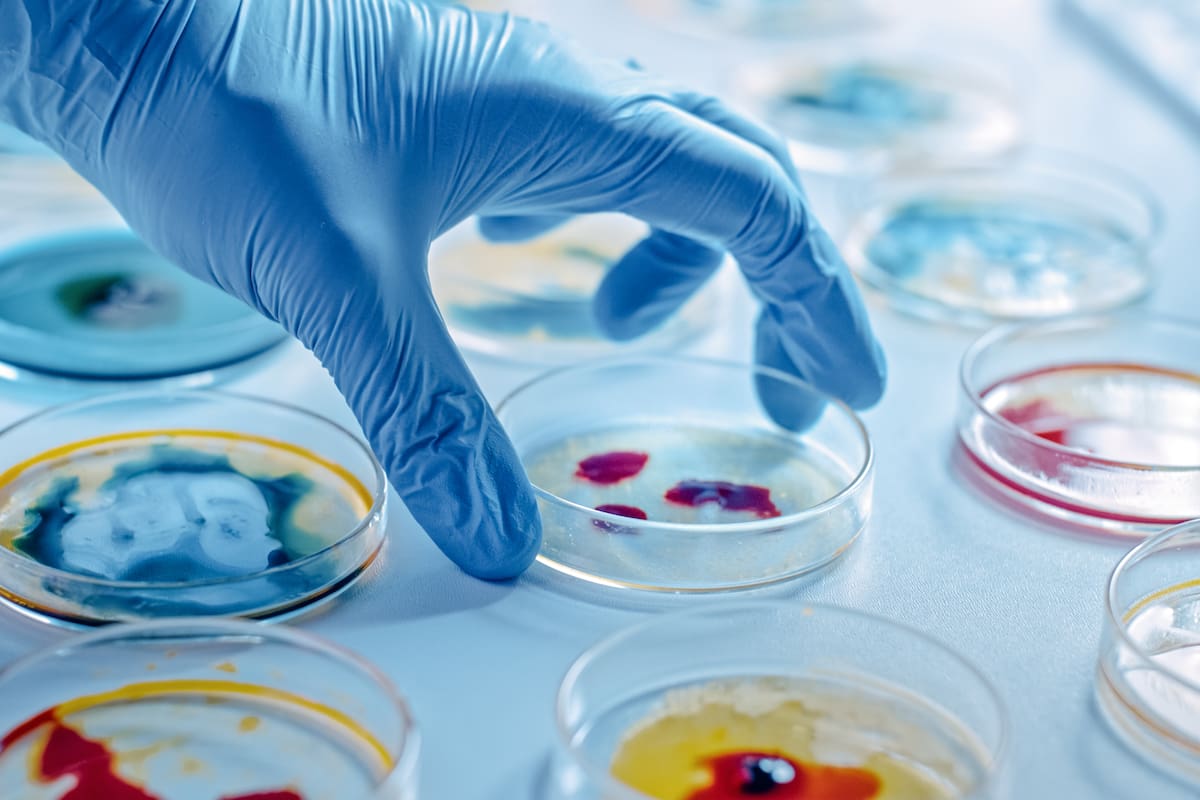

Científicos descubren una nueva parte del sistema inmunológico que podría ayudar en la crisis de los antibóticos
Este descubrimiento podría transformar el tratamiento de enfermedades infecciosas.
Un equipo de investigadores ha identificado una parte desconocida del sistema inmunológico que podría representar una fuente inexplorada de antibióticos naturales. Este descubrimiento podría transformar el tratamiento de enfermedades infecciosas y ofrecer una alternativa eficaz ante la creciente resistencia a los antibacterianos tradicionales.
Un descubrimiento revolucionario
El estudio, publicado en la revista Nature, fue financiado por el Consejo Europeo de Investigación y reveló que los proteasomas, estructuras celulares encargadas de degradar proteínas, también desempeñan un papel clave en la detección de bacterias dentro de las células. Esta capacidad permite a los proteasomas activar defensas naturales contra los microorganismos patógenos y frenar su crecimiento.
El profesor Yifat Merbl, del Instituto Weizmann de Ciencias, calificó el hallazgo como “emocionante” y destacó que este nuevo mecanismo de inmunidad está presente en todas las células del cuerpo, lo que podría llevar al desarrollo de una nueva clase de antibióticos naturales. Por su parte, el profesor Danile Davis, de Imperial College London, consideró los resultados como “muy interesantes”, aunque advirtió que su aplicación como tratamiento antibiótico requerirá aún tiempo y pruebas adicionales.
La urgencia de nuevas soluciones
La resistencia a los antimicrobianos (RAM) es una preocupación global. Según la Organización Mundial de la Salud, el uso excesivo e indebido de antibióticos ha acelerado la adaptación de los patógenos, volviendo ineficaces muchos tratamientos.
El informe señala que la crisis se ha agravado por la prescripción innecesaria de antibióticos para tratar infecciones virales y por el deterioro de las instalaciones hospitalarias, lo que dificulta el control de infecciones.
Un problema actual, no del futuro
El Dr. Colin Brown, subdirector de la Agencia de Seguridad Sanitaria del Reino Unido, enfatizó en enero que la resistencia a los antimicrobianos no es un problema del mañana, sino una crisis que ya está ocurriendo y que causa más de un millón de muertes al año en todo el mundo. Advirtió que sin acciones contundentes, la disponibilidad de tratamientos efectivos disminuirá, poniendo en riesgo la capacidad de los sistemas de salud para contener infecciones.
Te puede interesar: El Parkinson afectará a más 25 millones de personas en el mundo en 2050
El reciente descubrimiento sobre los proteasomas podría ser un paso clave para desarrollar estrategias terapéuticas innovadoras en la lucha contra las enfermedades infecciosas. A medida que los científicos continúan investigando su aplicación en tratamientos, el hallazgo brinda una nueva esperanza en la batalla contra la resistencia bacteriana.
Con información de The Independent.
Sigue nuestro canal de WhatsApp
Recibe las noticias más importantes del día. Da click aquí
Te recomendamos

¿Sabías que puedes vivir sin estómago, pero no sin hígado?

¿Sabías que algunos animales pueden ver la luz ultravioleta, pero nosotros no?

Científicos crearon nanorobots magnéticos para eliminar la sensibilidad dental en solo 20 minutos, penetrando hasta 500 micrómetros dentro del diente para sellar la dentina desde el interior, lo que daría alivio duradero sin necesidad de usar pastas especiales o ir al dentista

Científicos crearon una serpiente de cascabel robótica y descubrieron que decenas de animales reaccionan con miedo al sonido incluso sin haber visto nunca a estos reptiles

Grupo Healy © Copyright Impresora y Editorial S.A. de C.V. Todos los derechos reservados